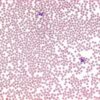

pH-indicator paper pH 1 – 10 Universal indicator
0 ₫
pH-indicator paper pH 1 – 10 Universal indicator là giấy chỉ thị pH được cung cấp ở dạng cuộn với kích thước phù hợp. Giấy dùng để phát hiện độ kiềm và độ acid của các dung dịch khác nhau. Thường được sử dụng trong các phòng thí nghiệm hóa học, sinh học , y tế hay trường học…
| Tên sản phẩm: | pH-indicator paper pH 1 – 10 Universal indicator |
| Code: | 1095250003 |
| Hãng- Xuất xứ: | Merck- Đức |
| Ứng dụng: |
– Phân biệt môi trường acid, base hay trung tính; – Xác định nhanh và chính xác pH của chất phân tích |
| Tính chất |
– pH < 3 cho màu đỏ – pH 3-6 cho màu cam hoặc màu vàng cam – pH=7 không đổi màu – pH > 7 cho màu xanh |
| Bảo quản | Bảo quản từ +15oC đến +25oC |
| Quy cách đóng gói: | 3 cuộn x 100 dải/ 1 hộp |
Hãy là người đầu tiên nhận xét “pH-indicator paper pH 1 – 10 Universal indicator” Hủy
Sản phẩm tương tự
Hóa chất thí nghiệm
Hóa chất thí nghiệm
CAL Check™ chuẩn Sắt thang cao, 0.00 và 1.50 mg/L HI96721-11 Hanna
Hóa chất thí nghiệm
Hóa chất thí nghiệm
Hóa chất thí nghiệm
CAL Check™ chuẩn Clo thang cao, 0.00 và 4.00 mg/L HI96734-11 Hanna
Hóa chất thí nghiệm
CAL Check™ Chuẩn Sắt Thang Thấp, 0.00 và 0.80 mg/L HI96746-11 Hanna
Hóa chất thí nghiệm
Hóa chất thí nghiệm

Đánh giá
Chưa có đánh giá nào.